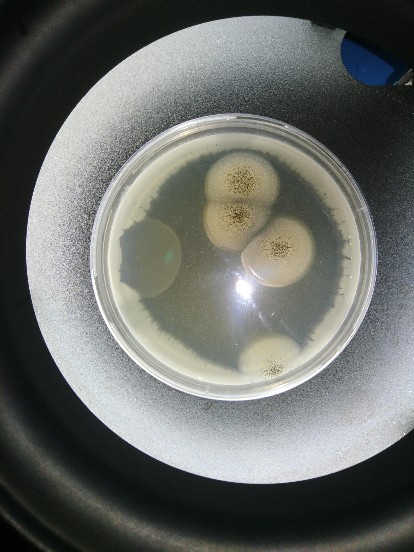
plíseň

Místo: Národní zemědělské muzeum, Kostelní 44, Praha 7 Akce: 27.9., od 17:00 do 22:00 (v budově muzea), zahájení přednášek 17:30 (Objevovna) Akce je realizována za finanční podpory Ročního vzdělávacího plánu Ministerstva zemědělství 2024. Akce se letos účastní 19 organizací a bude mít 27 stanovišť a 9 přednášek. https://bit.ly/3BcAL8Q Národní zemědělské muzeum Praha | Noc vědců (nocvedcu.cz) #zemedelskaveda #nocvedcu2024 #nocvedcu #nocvedcuvnzm #zemedelskemuzeum…
Pozvánka ZDE
Dne 14. 5. 2023 proběhly ve VÚPP, v.v.i. přednášky na téma „Senzorická analýza v praxi“, „Správná praxe skladování potravin“ a „3D tisk a jeho využití“, během kterých žáci druhého stupně základní školy T. G. Masaryka v Mnichovicích získali aktuální informace z oborů Analýza potravin (senzorické hodnocení, skladování potravin) a Potravinářské technologie (3 D tisk) v rozsahu vhodném pro věk žáků. Přednášky proběhly v rámci aktivity…

Výzkumný ústav potravinářský Praha, v.v.i. se zúčastní ve dnech 9. – 12. 5. 2024 2. ročníku veletrhu CZECH FOOD EXPO na výstavišti v Českých Budějovicích, pavilon T1. Výzkumný ústav bude prezentovat svou práci a aktivity v rámci stánku Ministerstva zemědělství. Na stánku ministerstva i u pultu výzkumného Vás budou čekat soutěže, kvízy a vzdělávací letáky věnované kvalitě a bezpečnosti potravin a…
Pro studenty Vyšší odborné školy zdravotnické (N1.A) v Praha 4 byla připravena ve Výzkumném ústavu potravinářském s podporou projektu výzkumné infrastruktury METROFOOD-CZ , grant MŠMT: LM2023064 praktika ze senzorické analýzy, kde byli studenti seznámeni se základními pojmy a teoretickými základy senzorické analýzy, s využitím senzorického hodnocení v potravinářské praxi apod. Nedílnou součástí bylo i osvojení si teoretických znalostí praktickým cvičením, při kterém studenti…
Pozvánka ZDE Přihláška ZDE
pořádaný v rámci programu STRATEGIE AV21 – POTRAVINY PRO BUDOUCNOST - CELIAKIE A POTRAVINOVÉ ALERGIE V ŠIRŠÍCH SOUVISLOSTECH http://vupp.carc.cz/domains/vupp.carc.cz/wp-content/uploads/2024/03/Pozvanka_19_4_2024_Strategie_AV21_Celiakie-a-alergie-v-sirsich-souvislostech.pdf
Všem našim kolegyním, kolegům, spolupracovníkům minulým i současným přejeme jenom to nejlepší do nového roku 2024.
6.prosince 2023 od 9.00 hod., Národní zemědělské muzeum s.p.o., velký sál, Kostelní 1300/4, Praha 7
Ve dnech 7.11.2023 a 8.11.2023 proběhly ve VÚPP,v.v.i. Dny otevřených dveří pro studenty středních škol. Žáci si vyslechli 3 zajímavé přednášky + 5 přednášek s praktickými ukázkami na téma: umělá inteligence a zdravá strava, moderní možnosti laboratorního dávkování vzorků, 3 D tisk v potravinářství, senzorická anylýza v tempu doby, metody stanovení lepku a alergenů v potravinách, aplikace vysokotlaké technologie prodloužení…
Datum konání: 1.12.2023 - 10.00 - 14.00 hod. Zveme Vás na již třetí workshop o možnostech identifikace rybích druhů se zaměřením na odhalování falšování potravin.Workshop je realizován v rámci projektu QK – Program aplikovaného výzkumu Ministerstva zemědělství na období 2017–2025, ZEMĚ QK1910231.

V rámci festivalu Týden Akademie věd ČR proběhnou ve VÚPP,v.v.i. Dny otevřených dveří - jedná se o celodenní program, kdy budou studentům středních škol nabídnuty ve dnech 7.11. a 8.11.2023 vždy 3 přednášky a 5 přednášek spojených s praktickými ukázkami.

Rádi bychom Vás pozvali dne 6.10.2023, 17.00 - 22:00 na akci NOC VĚDCŮ, která se bude konat v Národním zemědělském muzeu v Praze, kde si u našeho stanoviště budete moci nechat otestovat potravinu, pokrm, pracovní plochu. PŘÍJEM VZORKŮ OD 17.hod.-19.hod.!!!
Dne 23. srpna 2023 proběhlo 7. zasedání Rady instituce VÚPP,v.v.i. Jediným bodem zasedání bylo výběrové řízení na funkci ředitele VÚPP, v.v.i. Jediným kandidátem pro výběrové řízení byl Ing. Marian Urban, Ph.D. Po krátké diskusi členové odhlasovali jednomyslně doporučit panu ministrovi jmenovat Ing. Mariana Urbana, Ph.D. do funkce ředitele instituce na další funkční období. Bližší informace jsou v přiloženém zápisu. Zápis…
Čestné prohlášení uchazeče o funkci ředitele - ke stažení ZDE
Dne 15. 5. proběhla exkurze studentů 1. ročníku magisterského studia VŠCHT, program Analýza potravin, Praha ve Výzkumném ústavu potravinářském Praha. Exkurze se zúčastnilo 18 studentů s doprovodem pedagoga. V rámci exkurze studenti navštívili technologickou halu, prohlédli si zařízení pro ošetření potravin vysokým tlakem, byla jim prezentována laboratoř pro detekci alergenů, PCR pracoviště, pracoviště pro testování receptur a analytické centrum. Na…
Dne 29. – 31. května 2023 proběhla ve Dvoře Králové nad Labem vědecká konference VITATOX zaměřená na benefity a rizika využívání antioxidantů, vitaminů, léčiv a stimulantů s ohledem na jejich toxicitu s využitím moderní analytické chemie. Zástupci VÚPP,v.v.i. se zúčastnili s posterem k projektu METROFOOD-CZ.
Veselé Velikonoce plné jarní pohody,lásky a dobré nálady.
Všem našim kolegyním, kolegům, spolupracovníkům minulým i současným přejeme jenom to nejlepší do nového roku, hlavně hodně zdraví, štěstí, lásky a spokojenosti!

V rámci Týdne AV ČR proběhly u nás 1. a 2. 11. 2022 DOD. Bylo to opravdu parádní! První den nás navštívilo 12 žáků Gymnázia Přípotoční a 14 žáků Malostranského gymnázia. Další den je vystřídalo celkem 30 žáků Střední průmyslové školy Podskalská. Ve VÚPP jsme jim ukázali, jak vypadá den vědce. Doufáme, že si žáci akci naplno užili a někdo…
Zajímáte se o vědu? Přemýšlíte, čím se věda momentálně zabývá? Co se děje v Akademii věd? Máme pro Vás řešení. V týdnu od 31.10. do 6.11. 2022 proběhne tradiční Týden Akademie věd České republiky. Podrobný program naleznete v následujícím odkazu: https://www.tydenavcr.cz/program/#c=0 Nejenom podrobnosti, zajímavosti a fotografie naleznete na FaceBooku AV (@tydenavcr) a na Instagramu pod hashtagy #tydenavcr a #zijuvedou.

Zajímají Vás zdravé a bezpečné potraviny? Zajímáte se o to, co jíte? Jste na správném místě! Spolek pro zdravou výživu pořádá dne 22.9.2022 od 9:00 do 16:00 v budově Národního zemědělského muzea konferenci na téma Zdravé a bezpečné potraviny. Jedná se již o 4. ročník série konferencí Současné trendy ve speciální výživě. Konference je ZDARMA a je po předchozí registraci…

Dne 19. 5. 2022 se uskuteční konference METROFOOD. Na konferenci se sejde široká paleta vědeckých i nevědeckých pracovníků, kteří se zabývají zemědělsko-potravinářským systémem. Povedou se více i méně vážné diskuze například o kvalitě a bezpečnosti potravin, dohledatelnosti a transparentnosti potravin, digitalizaci atd. Konference se můžete zúčastnit osobně, případně prostřednictvím vzdáleného přístupu (přenosem). Konference se uskuteční na the University of Agronomic…

Jak už nadpis vypovídá, Čechům se do konzumace moc nechce. Dle Českého statistického úřadu jsme spotřebovali za rok 2021 3,6 kg luštěnin na osobu a rok. Dle Světové zdravotnické organizace by ale každý člověk měl sníst 0,5 kg/týden, tj. 26 kg za rok! Jak toho ale docílit? Rajská polévka zahuštěná luštěninou O tom, jaké mají luštěniny benefity toho bylo sepsáno…

Dne 25. 1. 2022 proběhl v Klubu techniků na Novotného lávce "Potravinářský úterek". Odpolednem provázel Ing. Milan Houška, CSc. jako přednášející. V rámci akce byly prezentovány výsledky výzkumu vybraných projektů VÚPP: - "České bylinky pro nové potraviny podporující zdraví populace," - "Potraviny s vysokým obsahem sulforafanu," - "Potraviny bez konzervantů," - "Innovative down-scaled FOod processing in boX," - "Potenciál chmelových…

Výzkumný ústav potravinářský Praha, v.v.i., Vysoká škola chemicko- technologická v Praze, Přírodovědecká fakulta Univerzity Karlovy a společnost BidFood pořádají workshop na téma METODY ODHALOVÁNÍ FALŠOVÁNÍ RYB. Akce se bude konat v Přírodovědecké fakultě Univerzity Karlovy v Praze (Krajinova posluchárna, 2. patro) v pátek 26. 11. 2021 od 13.00 do 16.00 hodin. Vstup je zdarma. Podrobný program je k náhledu zde.…

Výroba potravin nemusí probíhat pouze ve velké továrně mimo město, ale třeba i v těsné blízkosti vašeho domova. Chtěli byste vědět, jak na to? Výzkumný ústav potravinářský Praha je zapojen do evropského projektu FOX - Food processing in a box (zpracování potravin v "krabici"). Projekt se zabývá transformací velkovýrobních technologií pro zpracování ovocných a zeleninových produktů na malé, flexibilní a…

Výzkumný ústav potravinářský Praha, v.v.i (VÚPP) se opět účastnil populární akce společnosti STOB (Stob Obezitě) Den zdraví, která proběhla 23. října 2021 v prostorách konferenčního centra City v Praze na Pankráci. Akce se konala pod záštitou ministra zdravotnictví ČR Mgr. et Mgr. Adama Vojtěcha, MHA a místostarosty MČ Prahy 4 Ing. Zdeňka Kováříka. Účastníci si mohli užít den plný pohybu,…

ČZU hledá zkušené výzkumné pracovníky. Partner VÚPP Česká zemědělská univerzita, Fakulta agrobiologie, potravinových a přírodních zdrojů oznamuje otevření nových pracovních pozic do nově vznikající výzkumné skupiny ERA Chair Research Group, konkrétně do výzkumného týmu k projektu H2020 DRIFT-FOOD. Více o pozicích na odkazech níže: Team members/Senior researchers in Food Technology Team members/Junior researchers in Food Technology

Ve čtvrtek 30. září proběhla ve velkém sále Národního zemědělského muzea v Praze na Letné odborná konference s názvem Současné trendy ve speciální výživě. 3. ročník pořádal Spolek pro zdravou výživu, z.s., odborným garantem akce byl Výzkumný ústav potravinářský Praha, v.v.i. (VÚPP). Na akci vystoupili přední odborníci z řad lékařů, výzkumných pracovníků a spolupracujících odborníků. Konference se zaměřila na problematiku…

V pátek 24. září 2021 byla Noc vědců. Výzkumný ústav potravinářský Praha, v.v.i. se k ní připojil v rámci Noci vědců v Národním zemědělském muzeu v Praze. Zástupci VÚPP si připravili pro návštěvníky muzea stanoviště s názvem Proměny potravin v čase. Zájemci si mohli prohlédnout výstavku potravin, na kterých se už podepsal čas, vyzkoušet si své znalosti ohledně správného ukládání…

Letos se konal již 5. ročník konference Platformy pro reformulace. Uskutečnila se 15. září 2021 v Národní technické knihovně pod záštitou ministra zemědělství ing. Miroslava Tomana, CSc., Ministerstva zdravotnictví ČR a předsedkyně Výboru pro zdravotnictví Poslanecké sněmovny Parlamentu ČR prof. MUDr. Věry Adámkové, CSc. Vystoupila celá řada uznávaných odborníků. Výzkumný ústav potravinářský zde reprezentoval výzkumnou infrastrukturu Metrofood-CZ, zkušební laboratoř VÚPP…

V sobotu 11. září proběhlo 16. Fórum celiaků – Gluten Free Prague Expo 2021. Výzkumný ústav potravinářský Praha, vvi. na akci reprezentovaly Ing. Jana Rysová a RNDr. Mgr. Zuzana Šmídová, Ph.D. Se zájemci diskutovaly o bezlepkových potravinách, gluten free dietě i receptech a o databázi bezlepkových potravin dostupné zdarma na www.potravinybezlepku.cz. Pro zájemci byly připraveny ochutnávky: bílý jogurt s růžemi (homogenát…

Zveme Vás na 16. Fórum celiaků, které se uskuteční v sobotu 11. 9. 2021 v hale č. 6 v areálu PVA EXPO Praha v Letňanech. Zde najdete program celého dne. Akce začíná v 9:30 hodin a končí pravidelně ve 15:00 hodin. Ing. Jana Rysová a RNDr. Bc. Zuzana Šmídová, Ph.D. z VÚPP budou na akci prezentovat Databázi bezlepkových potravin a…

V posledních srpnových dnech se zástupci Výzkumného ústavu potravinářského Praha, v.v.i. (VÚPP) účastnili tradičního agrosalonu Země živitelka v Českých Budějovicích. Návštěvníci 47. ročníku největší a nejvýznamnější veletrhu svého typu zaměřujícího se na zemědělský sektor napříč všemi jeho obory v České republice a na Slovensku se mohli setkat na stánku Věda a výzkum - resortní organizace MZe s ředitelem VÚPP Ing.…

Nabízeno k inzerci Osobní automobil ŠKODA Fabia 1.4 16V Classic 3A57443 TMBJC26Y844077461 1 390 1 170 2004 Osobní automobil 55 BA 5 109 000 Fotografie Kontakt Jaromír Smékal Vedoucí hospodářské správy +420 296 792 434 +420 602 468 235 Jaromir.smekal@vupp.cz www.vupp.cz

V pátek 5. února 2021 v 10:00 hodin proběhne tisková konference a křest nového výrobku firmy KITL. Na trh přichází unikátní sirup Kitl Syrob Růžový květ v limitované edici, na kterém spolupracovali Výzkumný ústav potravinářský Praha a Výzkumný ústav rostlinné výroby Praha společně s firmou Kitl. Akce se uskuteční v prostorách Výzkumného ústavu rostlinné výroby v Praze (Drnovská 507/73, Praha…

V rámci letošního online ročníku oblíbené akce Noc vědců 2020 připravil Výzkumný ústav potravinářský Praha, v.v.i. pestrý program. V pátek 27.11.2020 od 17.00 hodin začíná ZDE blok přednášek, workshopů, výstav, prohlídek a dalších akcí v oblasti zemědělských a potravinářských věd nejen z našeho ústavu. Výzkumný ústav potravinářský Praha, v.v.i. připravil celkem 9 přednášek a jednu výstavu Potraviny jak je neznáte…

Odkazujeme na článek Z jídla mizí bílý jed. Výrobci zkoušejí sladit jinak, který vyšel 15.9.2020 na seznamzpravy.cz. Na snahu výrobců sladit jinak reaguje za Výzkumný ústav potravinářský ing. Markéta Begany. Z článku vybíráme: Podle Markéty Begany z Výzkumného ústavu potravinářského Praha jsou na českém trhu další výrobky bez přidaného cukru. Ne vždy je ale hra výrobce na nízký obsah cukru…

15. Fórum celiaků Gluten Free Prague Expo 2020 má své náhradní datum a vy se jako obvykle můžete těšít na přednáškové bloky a trh bezlepkových výrobků, a to vše v hale č. 6 v PVA Expo Praha :) Výzkumný ústav potravinářský Praha, v.v.i. připravil jako každý rok poradnu pro návštěvníky akce. Můžete se zeptat na cokoliv z oblasti bezlepkových potravin,…

Zveme Vás na 15. Fórum celiaků, které se uskuteční v sobotu 5.9.2020 v areálu PVA Letňany. V příloze najdete program celého dne. Akce začíná v 9.30 hodin a končí pravidelně ve 15.00 hodin. VÚPP bude na akci prezentovat Databázi bezlepkových potravin a další související témata. Ve 13.30 začíná diskuzní fórum na téma Bezlepková dieta z pohledu pacientů a potravinového práva,…

V rámci 30. ročníku AKADEMICKÝCH TÝDNŮ, které se uskuteční v termínu 25.7.-28.8..2020 ve Sněžném v Orlických horách se uskuteční i přednáška naší kolegyně RNDr. , Bc. Zuzany Śmídové, Ph.D. na téma Bezlepková dieta, fakta a mýty. Přednáška se uskuteční ve středu 29.7.2020 v 10.45 hodin. Bližší informace najdete na www.akademicketydny.cz

Čas od času se vynoří otázka, zda je žitný chléb vhodný při bezlepkové dietě. Je všeobecně známo, že při bezlepkové dietě je zakázáno konzumovat všechny druhy pšenice, žito i ječmen i jejich křížence. Přesto se především na sociálních sítích a dokonce i v knihách objevuje, že kváskový žitný chléb mohou vyzkoušet i lidé s celiakií. Změřit obsah lepku v pšeničném/žitném…

... aneb začínáme naživo. První akce po koronavirové pauze. Naše kolegyně dr. Zuzana Šmídová vystoupí zítra, tj. v úterý 9.6.2020 od 18.00 hodin v Horká vana v Českých Budějovicích. Tak neváhejte a pokud Vás toto téma zajímá, slibujeme, že se dozvíte vše podstatné. Např. zda je cukr skutečně škodlivý, jaký je rozdíl mezi cukrem a sacharidy, co je to nízkosacharidová…

Milí učitelé, vzhledem k nastalé situaci je nutné všechny prezentační akce zrušit a posunout na pozdější termín. V případě zájmu o informace týkající se prezentace výukové sady, objednávek, ceny, termínu dodávky a dalších nás prosím kontaktujte na helena.kavanova@vupp.cz nebo mb.: 737287024. V případě, že budou všechna preventivní opatření zrušena a budeme moci vypsat nový termín, vás budeme ihned informovat. Všechny…

Ukázalo se, že v jídle, které jíme skoro každý den je tolik cukru, že z něj včely dokázaly dokonce vyrobit med.... Sdílíme reklamní spot prodejen Náš grunt a také varujeme před potravinami s vysokým obsahem přidaného cukru.... https://www.facebook.com/NasGrunt/videos/954283297961780/

Výzkumný ústav potravinářský Praha, v.v.i. uvedl v lednu na trh zajímavou učební novinku pro studenty chemie a biologie zejména středních a vyšších odborných škol s názvem Výuková sada pro detekci DNA vybraných druhů ryb PCR metodou. Sada umožňuje praktické procvičení metod molekulární biologie, polymerázové řetězové reakce (PCR) a horizontální gelové elektroforézy. Je určena pro čtyři skupiny studentů, kdy každá skupina…

Zveřejnil: bielak v kategorii Aktuality Články pro média
Výzkumný ústav potravinářský Praha, v.v.i. Ing. Jana Rysová, RNDr. Bc. Zuzana Šmídová, Ph. D. Voda tvoří podle věku 45-70 % lidského těla, proto je hospodaření s vodou důležité pro zachování zdraví. Voda je nepostradatelná pro rozpouštění a transport živin, výměnu látkovou a vylučování odpadních látek. Zajišťuje funkci jednotlivých orgánů, stabilitu vnitřního prostředí a podílí se na regulaci tělesné teploty. Při…

Výzkumný ústav potravinářský Praha, v.v.i. v pořadu Českého rozhlasu Dvojka. Ing. Markéta Begany se spolu s Janem Tunou ve čtvrtek 30.1.2020 představila v pořadu Dva na Dvojce - Spotřebitelská poradna v rámci rozhovoru na téma závislost na rychlém občerstvení. Rozhovor si můžete poslechnout ZDE. Hamburgery, hranolky, smažená masíčka, colové nápoje a tak dále. Miliardy lidí po celém světě toto ne…

Výzkumný ústav potravinářský Praha, v.v.i. zahájil prodej výukové sady pro detekci DNA vybraných druhů ryb PCR metodou. Sada je určena pro studenty gymnázií, středních a vysokých škol s přírodovědným zaměřením, vyšších odborných škol potravinářských, pro přírodovědné kroužky, domy dětí a mládeže, nadšence, školící pracoviště a další instituce. Sada umožňuje praktické procvičení metod molekulární biologie, polymerázové řetězové reakce (PCR) a horizontální…

Akce se za Výzkumný ústav potravinářský Praha, v.v.i. účastní vedoucí výzkumu Ing. Ivana Laknerová a Ing. Pavla Novotná. Ústav mléka, tuků a kosmetiky VŠCHT Praha, Českomoravský svaz mlékárenský a Odborná skupina pro potravinářskou a agrikulturní chemii České společnosti chemické pořádají ve dnech 22.-23.1.2020 18. ročník Celostátních přehlídek sýrů a konferenci Mléko a sýry o nových poznatcích v chemii, mikrobiologii a technologii…

Výzkumný ústav potravinářský Praha, v.v.i. zastupují v Lisabonu (Portugalsko) ředitel ústavu Ing. Marian Urban, Ph. D. a náměstek pro vědu a výzkum Ing. Aleš Landfeld. Setkání probíhá ve dnech 9.-10.1.2020. Akce se účastní 75 zástupců z 18 zemí Evropy, kteří zastupují 48 partnerských institucí (20 příjemců a 28 propojených třetích stran). Výzkumná infrastruktura METROFOOD zahrnuje více jak 2.200 výzkumných pracovníků.…

Sůl útočí. Pozor na to, v čem všem je skryta a co způsobuje V pořadu účinkuje Ing. Jana Rysová z Výzkumného ústavu potravinářského Praha. Skrytá sůl v mnoha potravinách nám vyvolává spoustu vážných zdravotních problémů a nemocí. Podívejte se na to, v čem všem je ukryta. A hlavně, v jak velkém množství. Podívejte se na nové A DOST! Aktuální díl…

Tajemství fast foodu: Vzniká na něm závislost, funguje jako droga. V pořadu účinkuje Ing. Markéta Begany z Výzkumného ústavu potravinářského Praha. Hamburgery, hranolky, smažená masíčka, colové nápoje a tak dále. Miliardy lidí po celém světě toto ne moc zdravé jídlo konzumují pomalu každý den. A vůbec netuší, že se vlastně nerozhodují sami za sebe. Ale že mix chutí je tak…

Nový díl pořadu A DOST! tentokrát o cukrech s RNDr. Bc Zuzanou Šmídovou, Ph. D. Jaké množství cukru najdete v nejznámějších výrobcích... Pořad se natáčel v budově Výzkumného ústavu potravinářského v Praze - Hostivaři. Aktuální díl si můžete pustit ZDE

PROGRAM TÝDEN VĚDY A TECHNIKY AV VE VÝZKUMNÉM ÚSTAVU POTRAVINÁŘSKÉM PRAHA, v.v.i. RADIOVÁ 1285/7, PRAHA 10 - HOSTIVAŘ 11.– 15. 11. 2018 (9.00 -13.00 hod.) Program pro školy Téma: Strava teenagerů Cílová skupina: studenti základních, středních a vysokých škol Odborná část: Strava teenagerů (Ing. Markéta Begany, RNDr. Bc. Zuzana Šmídová, Ph.D.) Cílem přednášky je seznámit posluchače se základy zdravého a…

Ve čtvrtek 24. října proběhla ve velkém sále Národního zemědělského muzea v Praze na Letné odborná konference s názvem Současné trendy ve speciální výživě. 2. ročník pořádal Spolek pro zdravou výživu, z.s., odborným garantem akce byl Výzkumný ústav potravinářský Praha, v.v.i. (VÚPP). Na akci vystoupili přední odborníci z řad lékařů, výzkumných pracovníků a spolupracujících odborníků. Konference se zaměřila na témata související se speciální…

Výzkumný ústav potravinářský Praha, v.v.i., Vysoká škola chemicko- technologická v Praze, Přírodovědecká fakulta Univerzity Karlovy, společnost BidFood a 1. lékařská fakulta Univerzity Karlovy a Všeobecná fakultní nemocnice v Praze pořádají v prostoru Charvátova sálu na III. interní klinice VFN, U nemocnice 1, Praha 2 workshop na téma NOVÉ PŘÍSTUPY K PRŮKAZU FALŠOVÁNÍ RYBÍHO MASA POMOCÍ GENOMOVÉ DNA. Akce se bude…

Zítra 8.10.2019 začíná v Pardubicích v hotelu Labe dvoudenní konference s názvem Dietní výživa 2019. Konferenci pořádá Společnost pro výživu, z.s. organizačně zajišťuje výživaservis s.r.o. Výzkumný ústav potravinářský Praha, v.v.i. se účastní prvního dne konference s prezentačním stánkem s informacemi o činnosti ústavu, národní infrastruktuře Metrofood a projektech, které se zabývají reformulacemi. Nebude chybět ani Databáze bezlepkových potravin. Dále jsme…

Díky Ing. Aleši Landfeldovi, náměstkovi pro vědu a výzkum, jsme měli skvělou prezentaci ústavu v České televizi, Studio 24, Speciál Noc vědců. Jedná se o desetiminutový rozhovor s Danielem Stachem na téma plýtvání potravinami a další související témata. Kdo jste ještě neviděli… - od minuty 6:40 začíná rozhovor s Alešem Landfeldem. https://www.ceskatelevize.cz/porady/10101491767-studio-ct24/219411058310927/

V pátek 27.9.2019 proběhl v Národním zemědělském muzeu v Praze již 13. ročník skvělé akce Noc Vědců 2019. Výzkumný ústav potravinářský Praha, v.v.i. se zúčastnil již potřetí, tentokrát ve složení Aleš Landfeld, Radko Pechar, Jiří Trnka, Pavla Novotná a Helena Kavanová. Na stánku jsme prezentovali problematiku reformulací, snižování obsahu soli a cukru v potravinách, bezlepkovou dietu, národní infrastrukturu Metrofood, jak…

Výzkumný ústav potravinářský se bude opět účastnit akce DEN ZDRAVÍ SE STOBEM 2019 tentokrát s tématikou naklíčených luštěnin. Budeme se věnovat výhodám naklíčených luštěnin, problematice domácího klíčení, proč je dobré jíst naklíčené luštěniny aj. Nebude chybět ani ochutnávka jídel z naklíčených luštěnin a ukázky jednotlivých druhů. Můžete se těšit na adzuki fazole, cizrnu, mungo fazole, sóju a další. Těším se…

ICEF13. Včera skončil v Melbourne, Austrálie 13. ročník Mezinárodního kongresu o strojírenství a potravinách - ICEF13 23.-26. září 201Výzkumný ústav potravinářský Praha, v.v.i. zastupoval Ing. Milan Houška, CSc. Zde si můžete prohlédnout momentky z akce. V případě zájmu o další informace z kongresu nás neváhejte kontaktovat.

Připravili jsme pro Vás soutěž o 5 volných vstupů pro dvě osoby na mezinárodní agrosalon ZEMĚ ŽIVITELKA 2019, který se koná od 22.8.2019 na Výstavišti v Českých Budějovicích. Napište alespoň 5 výrobků, na jejichž vývoji a výzkumu se Výzkumný ústav potravinářský Praha, v.v.i. v minulých letech spolupracoval. Nápovědu můžete najít v tomto článku Centrum transferu technologií (CTT) v potravinářském ústavu…

Výzkumný ústav potravinářský Praha, v.v.i. Vás zve na 46. ročník mezinárodního agrosalonu ZEMĚ ŽIVITELKA s podtitulem Výzvy českého zemědělství. Akce se uskuteční v termínu 22.-27.8.2019 již tradičně na Výstavišti v Českých Budějovicích. Výzkumný ústav potravinářský Praha , v.v.i. spolupracuje na vývoji mnoha druhů výrobků, ty nejznámější můžete přijít ochutnat do naší expozice (stánek 402, vedle pavilonu T1). Najdete zde bezlepkové…

Kolegové z Centra transferu technologií VÚPP, v.v.i. ing. Aleš Landfeld, Martin Hofman a ing. Jiří Trnka se právě teď školí v prostorách CTT Masarykovy univerzity v Brně v oblasti dotačních projektů na provoz a činnosti TT aj. Centrum pro transfer technologií MUNI připravilo již 2. ročník stáží pro pracovníky z transferu technologií a souvisejících oblastí. Stáže probíhají v termínu 29.7.…

Ve dnech 6.- 8.6.2019 se konal v Praze Veletrh vědy Akademie věd České republiky. V areálu PVA EXPO PRAHA se představilo na stovku vystavovatelů především z řad ústavů Akademie věd. Výzkumný ústav potravinářský Praha, v.v.i vyslal na akci své zástupce, aby zjistili možnosti spolupráce v rámci příštích ročníků. Ing. Jiří Trnka a Ing. Pavla Novotná si prohlédli expozice a zúčastnili…

Nízká spotřeba luštěnin v České republice je způsobena tím, že luštěniny obecně obsahují kromě kvalitních druhů bílkovin i vyšší sacharidy, tzv. oligosacharidy. Ty jsou v lidském trávicím traktu nestravitelné a v tlustém střevě nastává jejich odbourávání mikroflórou za vzniku plynu, který způsobuje nadýmání. Odbourání oligosacharidů však lze docílit naklíčením luštěnin. Takový výchozí materiál umožňuje připravit pokrmy, které nadýmání nezpůsobí a…

Výzkumný ústav potravinářský Praha, v.v.i. pronajímá část svých volných prostor v areálu na ulici Radiová v Praze 10 - Hostivaři. Jedná se o pronájem nebytových prostor - kanceláře, laboratoře, sklady, soc. zařízení a chodby o celkové výměře cca 1000m2 ve 3.NP hlavní budovy. K pronajímaným prostorům lze využít parkoviště před objektem s počtem stání 10 - 20 míst. Areál je celoročně…

Výzkumný ústav potravinářský Praha, v.v.i. , Česká zemědělská univerzita v Praze a Vysoká škola chemicko-technologická v Praze jsou členy sítě evropské výzkumné infrastruktury METROFOOD. Jak uvádí časopis Zemědělec 51/2018 ze dne 17.12.2018 s odkazem na tiskovou zprávu ČZU je součástí infrastruktury 48 partnerů ze 17 zemí. Metrofood sdružuje odborníky v potravinářství, na než se mohou obracet potravinářské podniky i veřejnost.…

Zemědělský výzkum, spol. s r. o. Troubsko pořádal tradiční konferenci s mezinárodní účastí pod názvem „Aktuální poznatky v pěstování, šlechtění, ochraně rostlin a zpracování produktů“ v hotelu Avanti ve dnech 21.-22. 11. 2018. Ing. Jana Rysová a Ing. Ivana Laknerová z Výzkumný ústav potravinářský Praha, vvi. se konference rovněž účastnily a prezentovaly zde výsledky své práce, která byla podpořena projektem NAZV QJ1510160…

Na začátku listopadu 2018 se Výzkumný ústav potravinářský Praha, v.v.i. opět připojil k vědeckému festivalu Týden vědy a techniky a otevřel svůj areál v pražské Hostivaři veřejnosti. Pro návštěvníky si připravil zajímavý a poučný program, který byl zaměřen na 3 témata: bezpečné zacházení s potravinami, naklíčené luštěniny, cukry a sladidla v potravinách a současné trendy ve speciální výživě. Program se…

Výzkumný ústav potravinářský Praha, v.v.i. spolupořádá v příštím roce již 57. evropské setkání odborníků a vědeckých pracovníků, kteří se zabývají vývojem, výzkumem a využívání technologie vysokého tlaku oblastech fyziky, chemie, potravinářství, geovědy, materiálového výzkumu a biologických věd. Mezinárodní konference "57th European High Pressure Research Group Meeting on High Pressure Science and Technology (EHPRG-2019)" se uskuteční od 1. do 6. září…

Výzkumný ústav potravinářský Praha, v.v.i. se připojuje k listopadové akci Týden vědy a techniky! Pro studenty středních škol bude připraven tématický program a workshop na úterý 6. listopadu a na čtvrtek 8. listopadu. V sobotu 10. listopadu pak výzkumný ústav chystá program pro širokou veřejnost a rodiny s dětmi. Program je zdarma. Vstup do areálu VÚPP je možný po předchozí…

V pátek 5. října 2018 od 17 do 22 hodin se v Národním zemědělském muzeu v Praze na Letné konala NOC VĚDCŮ. Výzkumný ústav potravinářský Praha připravil pro návštěvníky poučnou expozici na téma Potraviny včera, dnes a zítra ve 3. patře muzea a dvě přednášky v Objevovně. U svého stanoviště tým z VÚPP ukazoval práci na laboratorních přístrojích (jako např. texturometr, viskoziometr a refraktometr). Dále…

Zveřejnil: bielak v kategorii Aktuality Nezařazené
Ministerstvo zemědělství vydalo v srpnu 2018 národní doporučení k problematice označování nezáměrného výskytu stopového množství látek nebo produktů vyvolávajících alergie nebo nesnášenlivost v potravinách. Doporučení si můžete přečíst zde.

V sobotu 8. září proběhla pod záštitou Ministerstva zemědělství akce Dožínky na Letné. Výzkumní ústav potravinářský Praha, v.v.i. se k oslavě zemědělství a potravinářství na Letenské plání v Praze také připojil. Pro návštěvníky si na svém stánku připravil prezentaci zaměřenou na bezlepkové potraviny a jejich výrobu. Současně byla otevřena i poradna o bezlepkových potravinách s ing. Janou Rysovou. Zájemci mohli…

Výzkumný ústav potravinářský Praha, v.v.i. (VÚPP) se i v letošním roce zúčastnil populárního zemědělského veletrhu Země živitelka v Českých Budějovicích (23.-28. 8. 2018). Kolegové z Centra transferu technologií (CTT) na stánku č. 402 v blízkosti pavilonu T1 představili nový video spot o VÚPP a jeho CTT. V průběhu veletrhu konzultovali se zástupci malých a středních firem možnost spolupráce s VÚPP,…

Dne 8. srpna 2018 se konala na České zemědělské univerzitě v Praze schůzka ohledně dalšího směřování a vývoje projektu METROFOOD v České republice. Přítomni byli za VÚPP Ing. Jitka Pinkrová Ph.D. a Ing. Lucie Dohnalová, dále zástupci ČZU, VŠCHT a zástupkyně MŠMT. METROFOOD – RI je mezinárodní konsorcium, které se primárně zaměřuje na potraviny a výživu. Evropským strategickým fórem pro výzkumné…

Centrum pro transfer technologií Masarykovy univerzity v Brně pořádá ve dnech 30. 7.- 8. 8. 2018 pro zájemce o danou tématiku stáže. Tým Centra transferu technologií při Výzkumném ústavu potravinářském Praha, v.v.i. vyslal své zástupce (Ing. Lucii Dohnalovou, Mgr. Helenu Kavanovou, Martina Hofmana, Ing. Ivetu Horníčkovou, MBA, Ing. Jiřího Trnku a Ing. Aleše Landfelda), aby získali cenné rady a zkušenosti…

V úterý 17. 7.2018 proběhla v Národním zemědělském muzeu za účasti ministra zemědělství Miroslava Tomana vernisáž výstavy Zahrada první republiky. Ministr Toman poděkoval muzejnímu týmu za realizaci projektu a ocenil práci bývalého ministra zemědělství Jurečky, kterému se podařilo spustit přeměnu zemědělského muzea v kvalitní vzdělávací instituci moderního typu. Návštěvníci měli možnost prohlédnout si vybrané expozice i překrásný střešní prostor s…

Mezinárodní projekt BakeSus, kterého je Výzkumný ústav potravinářský Praha, v.v.i. aktivním partnerem, se blíží do svého finále a pokračuje posledním pracovním setkáním, tentokrát v historickém italském městě Perugia. Studijní materiály pro kurz zabývající se kvalitou a bezpečností potravin v pekárenském a cukrářském sektoru jsou připraveny pro otestování na prvních dobrovolnících. Jednání v Itálii se účastní také Ing. Marian Urban, PhD. z VÚPP. Projekt…

Ve dnech 19.-20. června 2018 se koná mezinárodní konference o nových potravinách v Národní technické knihovně v Praze. Konference se účastní také zástupci VÚPP a kolegové z Centra transferu technologií. Cílem konference organizované Ministerstvem zemědělství je předání nových informací, především v oblasti právních předpisů a sdílení zkušeností těch, kteří v oblasti nových potravin působí. Témata, o kterých se bude hovořit: nové nařízení…

Výzkumný ústav potravinářský Praha, v.v.i. oslavil v dubnu 2018 již 60 let od svého založení. V roce 1958 vznikl jako Ústřední výzkumný ústav potravinářského průmyslu. V návaznosti na toto jubileum proběhla 14. června oslava v sídle výzkumného ústavu za účasti současných i několika bývalých zaměstnanců VÚPP. Součástí programu bylo krájení narozeninového dortu, společné fotografování a výstava fotek, které připomněly historii ústavu.

V sobotu 2. června 2018 pořádal Ústav analýzy potravin a výživy VŠCHT Praha seminář Bezpečná výživa - netradiční potraviny, potraviny nového typu a doplňky II. Celodenní seminář moderoval Doc. Ing. Jan Pánek, CSc. Na semináři vystoupil také ředitel VÚPP Ing. Pavel Skřivan, CSc. s přednáškou o současném stavu ve výrobě bezlepkových potravin. Vysvětlil technologický termín "lepek" z hlediska cereální technologie, základní…

Kolegové z Centra transferu technologií při VÚPP se účastní ve dnech 31. 5. - 1. 6. 2018 ve Vědeckotechnickém parku 5. workshopu technologického transferu Univerzity Palackého v Olomouci. Na workshopu 3 pilíře technologického transferu se účastníci zaměřují na reálné zkušenosti z přípravy technologií k transferu, otázky duševního vlastnictví a kdy a jak využívat průmyslově-právní ochranu pro transfer technologií. Jako řečníci…

Ve dnech 28.-30. května 2018 pořádá Česká společnost chemická Sympozium o nových směrech výroby a hodnocení potravin ve Skalském Dvoře. Společně s VŠCHT je VÚPP i v tomto roce spolupořadatelem tohoto setkání pracovníků potravinářských, zemědělských a navazujících oborů. Program již 48. symposia je orientován na nové směry ve výrobě a hodnocení potravin se zaměřením na bílkoviny, lipidy, sacharidy, vitaminy, minerální…

V úterý 22. 5. 2018 se Ing. Pavla Novotná, Mgr. Helena Kavanová a Mgr. Hana Vondráčková z Výzkumného ústavu potravinářského Praha, v.v.i účastnily konference Školní stravování 2018 od Společnosti pro výživu v Pardubicích. Na konferenci v rámci doprovodného programu měly kolegyně možnost představit výsledky projektu o naklíčených luštěninách. Tato prezentace podpořila i blok přednášek, které byly věnované a zaměřené právě…

V sobotu 19. května 2018 proběhlo 13. fórum celiaků pod názvem Gluten Free Prague Expo 2018 na výstavišti PVA v pražských Letňanech. Akci každoročně připravuje Společnost pro bezlepkovou dietu, z.s. u příležitosti mezinárodního Dne celiakie. Výzkumný ústav potravinářský Praha, v.v.i. se dlouhodobě zabývá bezlepkovou výživou a potravinami. Spravuje a neustále aktualizuje svoji databázi bezlepkových potravin, která je dostupná zdarma na…

Zástupci Centra transferu technologií při VÚPP se ve čtvrtek 17. května 2018 zúčastnili 6. národní konference transferu v Techmania Sience centru v Plzni. Na konferenci vystoupili domácí i zahraniční hosté a diskutovali s účastníky o možnostech a úskalích transferu technologií v České republice. Mezi nejzajímavější a pro nás nejpřínosnější přednášky patřila prezentace Transfer technologií v oblasti zdravotnictví od Vladimíra Velebného…

Výzkumný ústav potravinářský Praha, v.v.i byl partnerem akce Zdravá Praha 15, která se konala 15. května 2018 na Veronském náměstí v Praze. Tento open air festival zdraví a zdravého životního stylu pořádala Městská část Prahy 15 s podporou Magistrátu hl. města Prahy. VÚPP se akce aktivně účastnil a na svém stánku prezentoval činnost ústavu. Odbornice z VÚPP, Ing. Pavla Novotná,…

Ve dnech 2. a 3. května 2018 proběhl celostátní Kongres nutričních terapeutů v Muzeu Policie ČR v Praze 2. Na tuto akci byli pozváni zástupci Výzkumného ústavu potravinářského Praha, Ing. Milan Houška, CSc. a Ing. Pavla Novotná, aby prezentovali činnost naší instituce a představili vybrané výsledky výzkumu. Ing. Houška přednesl prezentaci o výzkumné činnosti, zakázkové činnosti VÚPP a o vybraných…

Ing. Miloš Beran a Ing. Josef Drahorád se účastnili mezinárodní vědecké konference BioVaria v německém Mnichově. Představili zde formou posteru novou technologii pro výrobu mikro a nanočástic (CASND), na které spolupracují také s ČVUT. Technologii demonstrovali pomocí popisu nového typu zařízení tzv. ATOMIZERu, který je určen pro sprejové nebulizační sušení. Prototyp tohoto zařízení kombinuje technologii sprejového sušení s technologií nebulizace…

V rámci oslav 60. výročí založení Výzkumného ústavu potravinářského Praha, v.v.i. proběhla ve čtvrtek 19. dubna ve velkém sále Národního zemědělského muzea v Praze na Letné odborná konference s názvem Současné trendy ve speciální výživě. Na akci vystoupili přední odborníci výzkumného ústavu, spolupracující odborníci a lékaři internisté. Účastníci konference z řad vědců, lékařů, zástupců státní správy, nutričních terapeutů i studentů…

V japonské Osace se konala na konci března 20. Mezinárodní konference o nanovědě a nanotechnologii (ICNN 2018: 20th International Conference on Nanoscience and Nanotechnology). Na konferenci vystoupili se svými přednáškami také odborníci z VÚPP, kteří se těmito technologiemi v České republice zabývají. Ing. Josef Drahorád, CSc. prezentoval poznatky týmu z VÚPP o alternativních způsobech výroby mikročásticových proteinů (název přednášky: Spray…

Není žádným tajemstvím, že mláto je odpadem při vaření piva. Vstupní surovinou je zrní ječmene, ze kterého se po naklíčení vyrábí slad. Po uvaření sladu a zcezení mladiny zůstane jako odpad mláto, které vyžaduje rychlé zpracování. Dosud je pivovarské mláto využíváno převážně jako zdroj energie (např. jako náplň do bioplynových stanic). V menší míře se mláto využívá jako přídavek do…

Výzkumný ústav potravinářský, v.v.i. začal pro svou výzkumnou činnost v oblasti analýzy potravin využívat nový kapalinový chromatograf Agilent Infinity 1260 ve spojení s hmotnostním detektorem typu trojitého kvadrupólu Agilent 6460 s patentovanou technologií ionizace (ESI Agilent Jet Stream Technology). Do budoucna tak bude možné pomocí LC-MS/MS analýzy zkoumat potraviny z nejrůznějších hledisek. Bude možné se zaměřovat na důležité látky, které…

Ministerstvo školství, mládeže a tělovýchovy ČR společně s neziskovou organizací Česká hlava Projekt, vyhlašuje již 12. ročník nejprestižnější soutěže pro talentovanou mládež v oblasti vědeckých a odborných prací České hlavičky. Neváhejte a přihlaste se! V letošním roce se opět budou předávat ceny v pěti kategoriích: Sanitas „Život a zdraví člověka“ - cena se uděluje za odborné práce a projekty z…

Na českém trhu se nabízí nový doplněk stravy pod názvem Eligin. Jde o koncentrovanou formu kvalitního BIO zázvoru a vitamínu C. Oficiálně byl tento doplněk stravy představen odborníky a výrobcem v pátek 23. dubna 2018 na tiskové konferenci na festivalu Evolution v Praze. Na jeho vývoji se podílela řada odborníků. Mezi nimi např. přední česká imunoložka prof. MUDr. Jiřina Bartůňková,…

Výzkumný ústav potravinářský, v.v.i má nový přístroj na měření vlastností mouky - Amylograf E firmy Brabender. Přístroj splňuje normu 126/1. Jeho použití je pro měření a záznam charakteristik chování moučných suspenzí při řízeném záhřevu. Lze tak stanovit průběhy mazovatění škrobu a nepřímo stanovit amylolytické aktivity obilovin, mouk, šrotu jakožto základních vlastností mouk a obilných produktů určených k pečení a vaření.…

Na Velký pátek 30. 3. 2018 bude spuštěna 1. výzva pro podávání žádostí o podporu inovačních projektů v Praze, podávat ji lze do 30. 4. 2018. Podnikatelské subjekty mohou žádat o služby výzkumných institucí až do výše 2 mil. Kč s podporou až 75 %. Pro možnost spolupráce s Výzkumným ústavem potravinářským Praha kontaktujte Ing. Jiřího Trnku na jiri.trnka@vupp.cz. Cílem…
Ing. Lucie Dohnalová hovořila 13. března 2018 v radioporadně Českého rozhlasu Hradec Králové na téma plísně v domácnostech. Vysvětlovala posluchačům co jsou to plísně, kde je můžeme ve svých domovech najít, jaká jsou jejich zdravotní rizika a jak je lze odstranit. Upozorňovala na to, že plísně se rozmnožují rozrůstáním mycelia a sporami. Spory jsou rozmnožovací útvary plísní. Z nich jsou…

Ing. Lucie Dohnalová byla hostem pořadu Polopatě, který měl premiéru v neděli 11. března 2018 na ČT1. Reportáž měla název Čistota půl zdraví a věnovala se čistotě v kuchyni. Naše kolegyně vysvětlovala moderátorovi pořadu Filipu Čapkovi a divákům, kde všude se můžete setkat s nežádoucími mikroorganismy a jak je v kuchyni minimalizovat. Uváděla souhrn praktických rad, jak správně skladovat potraviny,…

Jak funguje transfer poznatků a technologií na univerzitě? Redakce portálu Vědavýzkum.cz mluvila s Hanou Kosovou, ředitelkou Centra pro přenos poznatků a technologií na Univerzitě Karlově, o službách, které centrum nabízí, o úspěchu projektu v programu GAMA i o překážkách, kterým oblast transferu stále čelí. "Z části je překážkou, že chybí větší povědomí o problematice transferu technologií a poznatků napříč systémem,…

Výzkumný ústav potravinářský Praha v rámci oslav 60 let od svého založení připravuje konferenci SOUČASNÉ TRENDY VE SPECIÁLNÍ VÝŽIVĚ. Akce je zaměřena na potravinové alergie a je určena jak pro širokou veřejnost, tak i pro odborníky. Uskuteční se ve čtvrtek 19. dubna 2018 v prostorách Národního zemědělského muzea v Praze na Letné. Program: 08:30 registrace 09:00–09:15 úvodní slovo 09:15–10:00 Celiakie…

Výzkumný ústav potravinářský Praha, v.v.i., v letošním roce slaví šedesát let od svého založení. 1. dubna 1958 vznikl jako Ústřední výzkumný ústav potravinářského průmyslu (ÚVÚPP) a velmi rychle se stal významným vědecko-výzkumným pracovištěm. Výzkumný ústav potravinářský Praha, v.v.i. je vědeckou institucí s dlouho tradicí. V letošním roce slaví již své 60. výročí. Je tedy na místě připomenout nejdůležitější milníky této instituce. Ústav se…

Ve středu 24. ledna 2018 obsadili kongresový sál Masarykovy koleje na Praze 6 milovníci sýrů. Konala se zde Celostátní přehlídka sýrů. Na programu bylo také hodnocení senzorické jakosti vybraných kategorií přírodních a tavených sýrů výrobců z ČR i ze zahraničí. V odborné hodnotitelské komisi nechyběly ani zástupkyně VÚPP Ing. Ivana Laknerová, která zasedala v komisi A1 a Ing. Pavla Novotná,…

V dnešních dnech se zástupci VÚPP účastní zasedání mezinárodního konsorcia pracujícího na projektu „BakeSus - Udržitelná a hygienicky nezávadná produkce v pekárenském sektoru skrze sdílení zkušeností“ v tureckém Mersinu. Jednání je nesmírně důležité z hlediska nastavení dalších kroků pro otestování vyvinutých vzdělávacích modulů pro studenty a pracovníky z pekárenského průmyslu. Projekt je realizován v rámci programu ERASMUS+.

RNDr. Zuzana Šmídová, Ph.D., členka bezlepkového týmu VÚPP, je autorkou přehledové práce o nové bezlepkové plodině, která nese název canihua. Tato poměrně málo známá plodina z Jižní Ameriky se v nedávné době objevila i na českém trhu. Pro lidi trpící nesnášenlivostí lepku představuje canihua (zejména její semena) možnost rozšíření jídelníčku o plodinu s kvalitním obsahem živin. Má příjemnou chuť a…

Ve středu 17. ledna 2018 od 10 hodin proběhlo v budově Výzkumného ústavu potravinářského Praha projednání a oponentura Periodické zprávy o využití institucionální podpory na dlouhodobý koncepční rozvoj výzkumné organizace za rok 2017. Projednání vedl Ing. Milan Houška, CSc., náměstek ředitele pro vědu a výzkum. Oponenti doc. Ing. Aleš Rajchl, Ph.D., vedoucí Ústavu konzervace potravin VŠCHT v Praze a prim.…

Ing. Pavel Skřivan, CSc. je spoluautorem inovovaných a nově vydaných skript Cereální chemie a technologie: Zpracování obilovin - mlýnská a těstárenská výroba. Skripta jsou přepracovanou první částí učebních textů, které slouží ke studiu cereální chemie a technologie v rámci oboru Technologie potravin. Bylo zachováno původní členění skript z roku 2004 autorů Příhoda, Skřivan, Hrušková, tedy na část věnovanou cereální chemii…

Ing. Jana Rysová a Ing. Dana Gabrovská, Ph. D. z Výzkumného ústavu potravinářského Praha, v.v.i. pro vás zpracovaly nejednoznačné téma enzymových preparátů. Text najdete také na webových stránkách Databáze bezlepkových potravin v sekci Publikace. Pro zájemce můžeme původní článek zaslat (v angličtině): Krishnareddy, S., Stier, K., Recanati, M., Lebwohl, B., Green, P.H.R.: Commercially available glutenases: a potential hazard in coeliac…

Středočeské inovační vouchery jsou finančním nástrojem podporujícím spolupráci malých a středních podniků ze Středočeského kraje s vysokými školami či výzkumnými organizacemi. Žádosti je možné podávat do konce ledna 2018 a jde o dotaci podnikatelským subjektům na služby výzkumných organizací. Dotace je ve výši 75%, min. výše dotace je 50 tis. Kč, max. výše pak 150 tis. Kč. Bližší informace včetně potřebných…

Rádi si s koncem roku připomínáme úspěchy našich kolegů. „Cena ministra zemědělství za nejlepší realizovaný výsledek výzkumu a experimentálního vývoje v roce 2014“ I. cena: Karel Kýhos, Výzkumný ústav potravinářský Praha, v.v.i., za vynález „Způsob inaktivace hmyzu pomocí řízené atmosféry a zařízení k provádění tohoto způsobu“. Zařízení umožňuje vakuovat uzavřený velkoobjemový vak se zrninou bez vakuové komory. Po odstranění vzduchu…

V minulých dnech vydalo prestižní světové odborné nakladatelství CRC Press, Taylor & Francis Group novinku s názvem High Pressure Processing of Fruit and Vegetable Products autorů Milana Houšky a Filipa Vinagre Marques da Silva. Ing. Milan Houška, CSc. je dlouholetým zaměstnancem Výzkumného ústavu potravinářského Praha, v.v.i., řešitelem mnoha i zahraničních projektů a autorem významného počtu patentů a užitných vzorů. Ing. Houška nyní…

V pátek 8.12.2017 oslavili zaměstnanci ústavu a naši hosté blížící se vánoční svátky. Akce se konala v jídelně ústavu s dárky a rozsvíceným vánočním stromem. Ing. Pavel Skřivan, CSc. pověřený vedením ústavu nejprve zhodnotil končící rok 2017 z pohledů úspěšných počinů i drobných neúspěchů a představil všem přítomným plán oslav 60. výročí založení ústavu, které si připomínáme v roce 2018.…

V úterý 12.12.2017 jsme ve Výzkumném ústavu potravinářském Praha uvítali vzácnou návštěvu z Městská část Praha 15. Paní Pavlína Nejedlíková, pověřená vedením Kanceláře starosty, paní Karolína Skrčená, PR manažerka a paní kronikářka Marie Zdeňková přijaly naše pozvání a přišly se na vlastní oči přesvědčit na čem, že to v ústavu pracujeme 😀Dámy si prohlédly naše laboratoře i přilehlé prostory, dozvěděly se informace…

Od května tohoto roku je novou členkou redakční rady vědeckého časopisu Czech Journal of Food Sciences vedoucí oddělení chemie, biochemie a mikrobiologie potravin našeho ústavu Ing. Jitka Pinkrová, Ph. D. BLAHOPŘEJEME! http://www.agriculturejournals.cz/web/cjfs/

Ve čtvrtek 9.11.2017 pokračovaly ve Výzkumném ústavu potravinářském Praha prohlídky pro návštěvníky akce TÝDEN VĚDY A TECHNIKY 2017. Studentům i laické veřejnosti jsme představili projekty týkající se nanotechnologie, Centrum transferu technologií, Databázi bezlepkových potravin a další aktivity. Všichni mohli ochutnat ovocné šťávy UGO i bezlepkové výrobky z pekáren Liška a Doktor Pekař. V UGO lahvičkách najdete nepasterované 100% ovocné a zeleninové…

Ve středu 15.11.2017 proběhne na půdě VÝZKUMNÉHO ÚSTAVU BRAMBORÁŘSKÉHO v Havlíčkově Brodě již poslední (šestý) z řady seminářů na téma nové technologie zpracování a skladování potravin z Programu rozvoje venkova. V rámci této akce se dozvíte například nejnovější informace o zpracování potravin vysokým tlakem, šetrném zpracování obilovin, HACCP - management kvality a bezpečnosti, možnostech podpory inovací z evropských fondů apod. Veškeré dotazy můžete…

V úterý 7.11.2017 jsme přivítali ve Výzkumném ústavu potravinářském Praha studenty několika tříd z gymnázia z Vlašimi a z Prahy. Studenti si vyslechli přednášku o bezlepkových potravinách, vyzkoušeli si práci v několika typech laboratoří, dále senzorickou analýzu potravin a ochutnali výrobky od firmy Bezlepková pekárna Liška a Bezlepková pekárna Doktor Pekař, všechny bezlepkové a všechny velmi dobré. Tímto našim dodavatelům…

Týden vědy a techniky jsme zahájili s dětmi ze 3. třídy ZŠ. Děti získaly informace o bezlepkových potravinách, vyzkoušely si test senzorických vlastností potravin, ochutnávaly bezlepkové výrobky z Pekárny Liška, poznávaly luštěniny, skládaly puzzle, pracovaly s pipetou a vyzkoušely mnoho dalších aktivit. Během tohoto týdne uvítáme i další studenty středních škol a gymnázií z Prahy a okolí. Pro veřejnost jsou…

Výzkumný ústav potravinářský Praha, v.v.i. Radiová 1285/7, 102 00 Praha 10 – Hostivař vyhlašuje výběrové řízení na pozici Výzkumný pracovník – analytický chemik – LC/MS Předpokládaný nástup od 1. 12. 2017 nebo dle dohody Pracovní úvazek: 1,0 (40 hodin/týden) Místo výkonu práce: Praha 10 - Hostivař Profil pracovního místa: provádění náročných analýz v oboru analýzy potravin vývoj, odzkoušení a zavádění…

Co je zdravé pro člověka, mělo by být zdravé i pro Zemi. Jak sladit jídelníček s tím, abychom dělali dobře i životnímu prostředí a celé naší společnosti? Přednáška pro odborníky na téma „Výživa s ohledem na budoucí generace: Flexitariánství a udržitelná strava“ pod záštitou iniciativy Vím, co jím a piju se bude konat 19. 10. 2017 od 14 hodin v Rezidenci Rosa, Střelničná 1680/8. Podrobnosti včetně obsahu přednášky…

Ve středu 18.10.2017 od 8.30 hodin se uskuteční v budově Centra polymerních systémů Univerzity Tomáše Bati ve Zlíně již 5. z cyklu seminářů na téma nové technologie zpracování a skladování potravin. Na programu je opět ochutnávka speciálního duhu ječného chleba, vyvinutého v rámci projektu MZe koordinovaného VÚPP. Na závěr programu proběhne exkurze do prostor moderního výzkumného centra. Akce je určena zástupcům…

V rámci semináře z programu PRV na téma nové technologie zpracování a skladování potravin, který se konal ve středu 4.10.2017, jsme navštívili České vinařství Chrámce. V období sklizně jsme si prohlédli prostory na zpracování a uskladnění vinné révy. Podívejte se na několik zajímavých obrázků zpracování hroznů, lisování mutu a výroby moštu a burčáku. V sobotu 14.10.2017 pořádá vinařství tradiční oslavu sklizně…

Rada Výzkumného ústavu potravinářského Praha, v.v.i. vyhlašuje výběrové řízení na funkci ředitele instituce Předpokládaný nástup od 1. 11. 2017 Požadavky: vzdělání VŠ technického nebo přírodovědného směru, vědecká hodnost praxe v manažerské funkci po dobu minimálně 5 let doložení odborné způsobilosti osvědčením o vzdělání, kvalifikaci či praxi státní občanství České republiky, občanství jiného členského státu Evropské unie nebo občanství státu, který je…

Dovolujeme si Vám nabídnout krátké fotografické ohlédnutí za letošním ročníkem Země živitelky. VÚPP se akce zúčastnil v rámci společného stánku s dalším sedmi v.v.i. rezortu zemědělství v pavilónu T1, bylo krásné počasí a Ing. Miloš Beran získal již poněkolikáté Cenu ministra zemědělství za nejlepší realizovaný výsledek výzkumu a experimentálního vývoje. V tomto roce za realizovaný výsledek s názvem "Technologie výroby…

Zástupci VÚPP Jiří Trnka, Hana Vondráčková a Helena Kavanová se ve čtvrtek 3.8.2017 zúčastnili pracovního setkání se zástupci Národního zemědělského muzea v Praze. Společně jednali o možné spolupráci v rámci akcí NMZ i dalších rezortních organizací a při přípravě jednotlivých expozicí a lektorských programů. Národní zemědělské muzeum otevřelo také expozici Potravinářství, která se nachází ve 3. patře rekonstruované budovy v…

Výzkumný ústav potravinářský Praha hostil ve dnech 13.-14.7.2017 zahraniční partnery projektu BakeSus - Udržitelná a hygienicky nezávadná produkce v pekárenském sektoru skrze sdílení zkušeností. Projekt si klade za cíl vývoj vzdělávacího programu zaměřeného na potravinovou bezpečnost v pekárenském a cukrárenském průmyslu. Akce se konala v prostorách ASZ ČR, Samcova 1177/1, Praha 1. Partneři: Univerzita Mersin (TR), Betelgeux s.l. (ES), VUPP (CZ), CIA…

Spolek pro zdravou výživu, z.s. ve spolupráci s Výzkumným ústavem potravinářským Praha, v.v.i. Vás srdečně zve na DEN BEZLEPKOVÝCH POTRAVIN, který se koná ve čtvrtek 22.6.2017 od 10.00 do 15.00 hodin v areálu výzkumného ústavu v Praze 10 - Hostivaři (zastávka Radiová, BUS 181, 182, 183). Dopolední program je určen pro základní a střední školy, odpolední blok potom pro širokou…

Výzkumný ústav potravinářský Praha, v. v. i. vyhlašuje výběrové řízení na pozici samostatný účetní. Požadujeme: min. středoškolské vzdělání znalost účetních systémů včetně mzdové problematiky prokazatelná zkušenost minimálně 5 let na podobné pozici zkušenosti v neziskové organizaci výhodou Náplň práce: provádí činnosti spojené s výpočtem mezd pro zaměstnance, vede mzdovou evidenci, provádí odvody příslušným institucím zpracovává účetní operace ústavu (za svěřenou oblast), spolupracuje při sestavení…

Výzkumný ústav potravinářský Praha, v. v. i. vyhlašuje výběrové řízení na pozici Vedoucí oddělení vnitřní správy Požadujeme: min. středoškolské vzdělání, vzdělání technického zaměření výhodou MS Office - uživatelská znalost minimálně 3 roky praxe na podobné pozici organizační a řídící schopnosti řidičský průkaz, aktivní řidič Náplň práce: odpovídá za úklid, ostrahu a údržbu přidělených objektů ve spolupráci s nadřízeným zajišťuje údržbu…

XLVII. Symposium o nových směrech výroby a hodnocení potravin se bude konat 22.-24.5.2017 v hotelu Skalský dvůr u Bystřice nad Pernštejnem. Program letošního symposia o nových směrech výroby a hodnocení potravin bude zahrnovat úvodní blok přednášek na téma "Inovativní technologie pro potraviny vysoké kvality", je uspořádáno formou přednášek a posterů s vydáním sborníku příspěvků v elektronické formě s ISSN a…

Dne 13. 5. 2017 od 8.00 do 18.00 hodin se koná DEN OTEVŘENÝCH DVEŘÍ ve vinařství v Chrámcích. Připomeneme si 50 let novodobé historie pěstování révy vinné na Mostecku. Všichni návštěvníci jsou srdečně zváni! http://www.ceske-vinarstvi.cz/ V objektu vinařství pořádá VÚPP ve středu 4.10.2017 exkurzi v rámci cyklu seminářů na téma nové technologie zpracování a skladování potravin. Bližší informace: http://vupp.carc.cz/domains/vupp.carc.cz/cs/cyklus-seminaru/#pozvanka

Ve středu 3.5.2017 proběhne ve Výzkumném ústavu pícninářském v Troubsku u Brna již třetí z řady seminářů na téma nové technologie zpracování a skladování potravin z Programu rozvoje venkova. V rámci této akce můžete ochutnat speciální druh ječného chleba, vyvinutého v rámci projektu MZe koordinovaného VÚPP. Ječný chleba vyrábí firma IREKS ENZYMA s.r.o. Akce je určena pro zástupce zemědělských a…

Ve středu 26. dubna 2017 se koná v konferenčním sále SVS ČR, Slezská 100/7, Praha 2 XXXVIII. ročník konference Potraviny zdraví a výživa 2017 s podtitulem Cukry – mýty a realita. Akci pořádá Společnost pro výživu ve spolupráci s Nadací výživa pro zdraví pod záštitou Úřadu pro potraviny MZe ČR a České technologické platformy pro potraviny. Moderují MUDr. Petr Tláskal, CSc.; Ing. Jan Pivoňka, Ph.D.…

Výzkumný ústav potravinářský Praha, v. v. i. vyhlašuje výběrové řízení na pozici Ekonomický náměstek ředitele Požadujeme: vysokoškolské vzdělání, ekonomické nebo technické praxe na obdobné pozici min 2 roky znalost české účetní a daňové legislativy znalost prostředí vědecké organizace výhodou znalost světového jazyka na komunikativní úrovni (AJ, NJ) kreativní a proaktivní přístup k práci, koncepční myšlení řidičský průkaz Náplň práce: vedení ekonomického…

Ve středu 12.4.2017 navštívil náš výzkumný ústav ministr zemědělství Ing. Marian Jurečka. Pan ministr se zúčastnil pravidelné porady vedení ústavu, navštívil výzkumné laboratoře a prohlédl si přilehlé prostory - technologickou halu a hospodářskou budovu, kde VÚPP plánuje ve spolupráci s ČZU vybudovat nový podnikatelský inkubátor, který se bude zaměřovat na podporu začínajících inovačních firem v oboru zemědělství a potravinářství. V…

Otvíráme registraci na 3. z cyklu seminářů z Programu rozvoje venkova, reg. č. 16/002/01210/120/000009, prosím registrujte se zde https://www.survio.com/survey/d/D3H2O0L9B9A2P2X1G Seminář se koná ve středu 3. 5. 2017 ve Výzkumném ústavu pícninářském v Troubsku https://www.vupt.cz

3. seminář na téma Nové technologie zpracování a skladování potravin z Programu rozvoje venkova, který se měl uskutečnit ve středu 12.4.2017 ve Vinařství Chrámce u Mostu se z technických důvodů přesouvá na středu 4.10.2017. O konkrétním programu Vás budeme informovat na začátku září 2017. Pokud nechcete tak dlouho čekat je možné využít termín 3.5.2017, kdy seminář pořádáme ve Výzkumném ústavu pícninářském…

Ing. Miloš Beran z oddělení potravinářských technologií, biotechnologií a inženýrství přivezl z Indie ocenění za nejlepší posterovou prezentaci v rámci konference ICNANO2017. http://www.vbripress.com/icnano/

Mladé smrkové výhonky, které pomáhají uvolňovat dýchací cesty a rozpouštět hleny, jsou základem nového sirupu Kitl Smrkáček. Čistě přírodní přípravek v BIO kvalitě vyvinuli společně odborníci z oblasti potravinářství a firmy Kitl, která je tradičním výrobcem zdravých sirupů. Smrkáček ocení zejména rodiče malých dětí, které trápí rýma či nachlazení a preferují přírodní způsoby léčby. „Kitl Smrkáček obsahuje pouze smrkové výhonky, třtinový cukr…

Program vzdělávacího semináře, které pořádá Výzkumný ústav potravinářský Praha, v.v.i. v rámci projektu Programu rozvoje venkova, reg. č. 16/002/01210/120/000009 dne 22.3.2017 na Jihočeské univerzitě v Českých Budějovicích. „Nové technologie zpracování a skladování potravin“ 8.30 – 9.00 Registrace, občerstvení 9.00 – 9.15 Zahájení, představení ústavu, organizační informace 9.15 – 10.00 Představení a ochutnávka nápoje na bázi piva ze smrkových suků – Ing. Milan…

Ve středu 29. března 2017 v 17:30 budou v panelové diskuzi “Hádej, co bude k večeři” hovořit o biotechnologiích v zemědělství a potravinářství, potravinách nového typu a o nejnovějších trendech ve stravovacích návycích experti z Odboru bezpečnosti potravin Ministerstva zemědělství ČR Jitka Götzová, Petr Beneš, Karolína Mikanová a ředitel Výzkumného ústavu potravinářského Marek Světlík. Panelisté jsou absolventy International Visitor Leadership Programs.

Program vzdělávacího semináře, které pořádá Výzkumný ústav potravinářský Praha, v.v.i. v rámci projektu Programu rozvoje venkova, reg. č. 16/002/01210/120/000009 dne 1. 3. 2017 v Technoparku Kralupy nad Vltavou. „Nové technologie zpracování a skladování potravin“ 9.00 – 9.30 Registrace, občerstvení 9.30 – 9.40 Zahájení, organizační informace 9.40 – 10.40 Šetrné postupy skladování a zpracování obilovin pro lidskou výživu - Ing. Pavel Skřivan, CSc.…

Obsazujeme novou pozici - výkonný asistent managementu pro vědu a výzkum. Zajímá Vás problematika kvality potravin? Máte vzdělání v některých z následujících oborů - potravinářská chemie, technologie, biotechnologie, farmacie nebo v některém z přírodovědeckých oborů? Máte praxi v oblasti výzkumu nebo potravinářské výroby? Zájemci hlaste se prosím do 28.2.2017 přímo panu řediteli na email marek.svetlik@vupp.cz http://vupp.carc.cz/domains/vupp.carc.cz/cs/volna-mista/#vykonny-asistent

Nové technologie zpracování a skladování potravin V rámci dotačního titulu Program rozvoje venkova pořádá Výzkumný ústav potravinářský pro potravinářské a zemědělské podniky cyklus seminářů (celkem 6) s názvem Nové technologie zpracování a skladování potravin. První ze seminářů se koná ve středu 1. 3. 2017 v Technoparku Kralupy nad Vltavou. Registrace na seminář je do 20.2.2017, počet účastníků je omezen. http://vupp.carc.cz/domains/vupp.carc.cz/cs/cyklus-seminaru/

Zveřejňujeme aktuální verzi výkladu k technické novele zákona 130/2002 Sb., která je výsledkem dohody s ministerstvem školství, mládeže a tělovýchovy. Materiál byl zároveň rozsáhle konzultován s dalšími poskytovateli. Bližší informace: www.vyzkum.cz http://vyzkum.cz/FrontAktualita.aspx?aktualita=797505

Ve čtvrtek 26.1.2017 proběhne od 10:00 hodin v budově Výzkumného ústavu potravinářského projednání a oponentura Periodické zprávy o využití institucionální podpory na dlouhodobý koncepční rozvoj výzkumné organizace za rok 2016. Projednání povede Ing. Pavel Skřivan, CSc., náměstek ředitele pro vědu a výzkum. Oponenti Prof. Ing. Jana Hajšlová, CSc., vedoucí Ústavu analýzy potravin a výživy VŠCHT v Praze, držitelka prestižního ocenění…

Ve středu 25.1.2017 proběhne od 10:00 hodin v budově Výzkumného ústavu potravinářského projednání závěrečné zprávy projektu MZe QJ1210257 s názvem Zlepšení nutričních, dietických a senzorických vlastností tuzemských, zejména alternativních a maloobjemových, obilovin a jejich mlýnských produktů technologickými postupy s využitím fermentačních účinků bakterií mléčného kvašení. Odpovědný řešitel: RNDr. Vladimír Erban, CSc., oponenti Prof. Ing. Ivana Capouchová, CSc. a Prof. Ing. Jaroslava Ehrenbergerová,…

Ve středu 18.1.2017 se v budově VUPP v Praze 10 - Hostivaři konalo projednání závěrečné zprávy projektu NAZV-MZe QJ1210258 s názvem Extrakce lignanů z dřevní hmoty a jejich využití v doplňcích stravy s významnými biologickými účinky, odpovědný řešitel: Ing. Milan Houška, CSc., oponenti Prof. Ing. Pavel Kalač, CSc Jihočeská univerzita České Budějovice a Ing. Eva Šimsová, firma AROCO spol. s r.o., Praha.

Vymysleli přípravek, který až pětkrát prodlouží trvanlivost ovoce a zeleniny Floridský start-up Apeel Sciences připravil řešení pro prodloužení životnosti ovoce a zeleniny od okamžiku, kdy je sklizené. V praxi by to mohlo znamenat nejen to, že se zkazí méně potravin během cesty z pole k zákazníkovi, ale také to, že se nemusí sklízet nedozrálé plody, které teprve během cesty „dojdou“.Zdroj:…

Výzkumný ústav potravinářský Praha, v. v. i. vyhlašuje výběrové řízení na pozici Senior Project Manager Požadujeme: vysokoškolské vzdělání, technické (nejlépe potravinářská chemie, potravinářská technologie, biotechnologie, farmacie) nebo přírodovědecké vědecká hodnost Ph.D. nebo CSc. v oboru praxe v oblasti výzkumu nebo potravinářské výroby praxe v oblasti projektového řízení znalost světového jazyka na komunikativní úrovni (AJ, NJ, FrJ) kreativní a proaktivní přístup k práci…

Od Nového roku dojde ke změnám podmínek pro dovoz neplněných želatinových kapslí určených k lidské spotřebě a některých potravinových doplňků obsahujících produkty živočišného původu do Evropské unie (EU). Některé produkty, které dosud při vstupu do EU nepodléhaly vstupní veterinární kontrole, budou od 1. ledna 2017 muset splňovat veterinární požadavky na dovoz a budou v místě vstupu do EU kontrolovány. Tyto produkty budou…

Výzkumný ústav potravinářský Praha, v. v. i. vyhlašuje výběrové na pozici Projektový manažer pro vědu a výzkum Požadujeme: vysokoškolské vzdělání, technické (nejlépe potravinářská chemie, potravinářská technologie, biotechnologie, farmacie) nebo přírodovědecké vědecká hodnost Ph.D. nebo CSc. v oboru praxe v oblasti výzkumu nebo potravinářské výroby praxe v oblasti projektového řízení znalost světového jazyka na komunikativní úrovni (AJ, NJ, FrJ) kreativní a proaktivní přístup…

V časopise Potravinářská revue č.6/2016 vyšel článek Pavla Skřivana a Marcely Slukové o mlýnských technologiích současnosti. Autoři se zamýšlejí nad novými technologiemi v oblasti zpracování obilovin z hlediska zdravé výživy, zejména zvýšení poptávky po výrobcích celozrnných a s vyšším obsahem vlákniny. Druhým důvodem je, že současné technologie jsou velmi složité, relativně energeticky náročné a nejsou variabilní z hlediska suroviny. Jaké…

Ministerstvo průmyslu a obchodu vyhlásilo dne 28. listopadu 2016 výzvy v následujících programech podpory: Inovace - Výzva III (inovační projekt), Úspory energie - Výzva II, Služby infrastruktury - Výzva III. Dne 29. listopadu 2016 byla vyhlášena Výzva III programu Aplikace. Texty výzev včetně jejich příloh jsou k dispozici na webu Agentury pro podnikání a inovace a Ministerstva průmyslu a obchodu.

Předseda Technologické agentury ČR Petr Očko převzal v pátek 25. listopadu 2016 v Bruselu z rukou Laure Reinhart z francouzské agentury Bpifrance roční předsednictví sítě 30 evropských inovačních agentur TAFTIE. Síť TAFTIE sdružuje 30 organizací z 28 evropských států. Mezi nejznámější patří například rakouská FFG, finská agentura TEKES, izraelský MATIMOP, polská agentura PARP, dánská DASTI a další. Za Českou republiku…

Evropská technologická platforma - TP Organics vydala 12 prioritních témat k programu Horizont 2020 2018/2020. Program obsahuje dva druhy projektů: 1) projekty zaměřené na přechod potravinových systémů v Evropě (7 témat) a 2) projekty, které řeší specifické potřeby v oblasti biopotravin a ekologického zemědělství (5 témat). TP Organics je Evropská technologická platforma (ETP) pro ekologické potraviny a zemědělství, sdružující velké, malé a…

Ve dnech 15. – 16.11. 2016 v Brně v hotelu Avanti uskuteční mezinárodní konference „Aktuální poznatky v pěstování, šlechtění, ochraně rostlin a zpracování produktů“. Konferenci pořádá Zemědělský výzkum, spol. s r. o. Troubsko. Za náš ústav se zúčastní Jana Rysová a Vladimír Erban. Konference je určena vědeckým a odborným pracovníkům, šlechtitelům a zemědělským poradcům i široké zemědělské veřejnosti a jejím cílem je prezentace nejnovějších…

Ve dnech 14.-15.11.2016 proběhne v sále Ministerstva zemědělství v Praze Biosummit 2016 - Tradiční setkání hlavních aktérů ekologického zemědělství v ČR s politiky a médii. Program a další informace najdete na webových stránkách biosummit.eu.http://www.biosummit.eu

Výzkumný ústav potravinářský Praha vyhlašuje výběrové řízení na pozici ekonomického náměstka.

V úterý 1.listopadu 2016 ve 13.00 hodin začalo v Praze ve Velkém sále paláce Žofín 204. Žofínské fórum na téma: Potraviny, kvalita a soběstačnost konané pod záštitou ministra zemědělství Mariana Jurečky. Diskuse o nejaktuálnějších otázkách našeho potravinářství. K čemu napomohl zákon o významné tržní síle? Jak je ochráněn trh s kvalitními potravinami? Zájmy výrobců a domácích dodavatelů vers. zahraniční obchodní řetězce…

Výzkumný ústav potravinářský Praha vstupuje do projektu Cesta pro mladé - cesta k uplatnění na trhu práce. Pokud jste studentem posledního ročníku VŠ, máte zájem pracovat v rámci stáže ve VUPP, získat tak praxi a vydělat nějakou tu korunu, kontaktujte manažera projektu na: jiri.trnka@vupp.cz. Nabízíme možnost uplatnění pro biology, chemiky, technology, potravináře i administrativní pracovníky. Plný text inzerátu: nabidka-stazi Bližší…

Výzkumný ústav potravinářský Praha ve spolupráci se Spolkem pro zdravou výživu plánuje začátkem roku 2017 založit v Praze Informační centrum pro zdravou výživu. Hlavním posláním centra bude poradenství v oblasti zdravé výživy a bezpečnosti potravin. Poskytneme nejen relevantní informace v oblasti podpory zdravého životního stylu a zdravého stravování, ale i speciální doporučení pro specifické skupiny obyvatel, kteří trpí některou z…

Ve dnech 20.-21.10.2016 se konal v sále na Novotného lávce 5 již 12. ročník mezinárodní konference Polysacharidů – Glycoscience 2016, která je zaměřena na průmyslovou výrobu a využití polysacharidů. V programu vystoupí i vědci z Výzkumného ústavu potravinářského Praha. Zúčastní se Pavel Skřivan, který je spoluautorem textu: The comparison of different milling processes on structure and properties of flour (poster) a Jitka…

Výzkumný ústav potravinářský Praha nabízí ve svém areálu k pronájmu samostatný, plně vybavený jednopatrový objekt, případně jeho část. Celková výměra těchto prostor činí 1080 m². Objekt je možno využít jako dílny, sklady či kanceláře. Ostraha a parkovací místa v areálu jsou zajištěny. Kontakt: Ing. Stanislav Schmidt, telefon 727 887 278

Ing. Miloš Beran byl oceněn za mimořádné výsledky ve výzkumu a experimentálním vývoji. Cena mu byla předána při slavnostním zahájení 43. ročníku výstavy Země živitelka v Českých Budějovicích dne 25. srpna 2016 za vynález „Poloprovozně ověřená enkapsulace probiotických mikroorganismů v biopolymerních mikročásticích nebulizací oxidem uhličitým“.

Výzkumný ústav potravinářský Praha nabízí provedení širokého spektra analytických rozborů surovin a potravinářských výrobků. Příloha:

Výzkumný ústav potravinářský Praha vyhlašuje výběrové řízení na pozici „Office asistant“. Přihlášky zasílejte do 10. 10. 2016 na adresu instituce nebo elektronicky na adresu elektronické pošty marek.svetlik@vupp.cz. Nástup možný okamžitě. Příloha:
